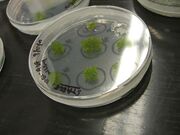

Uploads by Jason R. Kelly
From OpenWetWare
Jump to navigationJump to search
This special page shows all uploaded files.
| Date | Name | Thumbnail | Size | Description |
|---|---|---|---|---|
| 23:37, 8 September 2008 | KC Glycerols.xls (file) | 23 KB | KC glycerols | |
| 23:36, 8 September 2008 | JKM Glycerols.xls (file) | 28 KB | JKM glycerols from endy lab | |
| 19:56, 12 July 2008 | Ginkgologo.PNG (file) | 7 KB | ||
| 05:14, 3 May 2008 | Moss3.jpg (file) |  |
2.72 MB | |
| 05:13, 3 May 2008 | Moss5.jpg (file) | |
2.65 MB | |
| 05:13, 3 May 2008 | Moss2.jpg (file) |  |
2.75 MB | |
| 05:13, 3 May 2008 | Moss1.jpg (file) |  |
2.76 MB | |
| 16:25, 23 April 2008 | Repressor sites.gif (file) |  |
38 KB | |
| 20:38, 14 April 2008 | Harris-mage.PNG (file) |  |
349 KB | harris presents MAGE |
| 22:29, 6 April 2008 | Oww onOLPC.jpg (file) |  |
71 KB | OWW on the OLPC XO computer |
| 09:25, 30 March 2008 | Proposed promoter standard2.JPG (file) | 10 KB | another option for BB promoter standard. | |
| 08:29, 30 March 2008 | Proposed promoter standard.JPG (file) | 10 KB | proposed promoter standard with fixed +1 site | |
| 08:19, 30 March 2008 | PromotersInReg.JPG (file) | 31 KB | ||
| 07:22, 30 March 2008 | Promoter table.JPG (file) |  |
99 KB | from Hawley & McClure, NAR Vol 11 (8) 1983 Table of nucleotide frequencies in the consensus e.coli sigma70 promoter |
| 04:30, 19 March 2008 | Torch-01-june.gif (file) |  |
12 KB | torch |
| 09:07, 24 February 2008 | Measkit promoter FACS.PNG (file) |  |
27 KB | |
| 09:02, 24 February 2008 | Promoter tester demo.jpg (file) |  |
23 KB | |
| 22:01, 6 February 2008 | GFP RBS relative dgfp 080204c.jpg (file) |  |
52 KB | RBS tester |
| 21:10, 25 January 2008 | SynBERC talk Reisinger.ppt (file) | 1.31 MB | Sarah Reisinger Talk for SynBERC slides from Leonard Katz | |
| 17:55, 24 January 2008 | OWWEmblem.png (file) |  |
21 KB | Reverted to earlier revision |
| 01:28, 24 January 2008 | SavePageButton.jpg (file) | 12 KB | Reverted to earlier revision | |
| 22:10, 23 January 2008 | Sortostat f2620.PNG (file) |  |
13 KB | |
| 14:53, 22 January 2008 | MeasKit inputs.JPG (file) |  |
8 KB | inputs to the measurement kit run on a gel to verify length and digestion |
| 17:19, 14 January 2008 | RBS tester colony PCR.JPG (file) |  |
8 KB | Colony PCR of 15 colonies following a construction using the RBS Measurement Kit |
| 15:30, 14 January 2008 | Psb3k3 Pcr prep.JPG (file) |  |
2 KB | preparatory PCR of psb3K3 on gel |
| 02:34, 27 December 2007 | FreeGenes.JPG (file) |  |
5 KB | |
| 15:52, 23 December 2007 | BarberoECDimage.JPG (file) |  |
16 KB | Image from Robbie Barbero, Grad student at MIT, from virus-based electrochromic devices that can change from clear to opaque when a charge is applied. |
| 14:53, 23 December 2007 | OWW-mithomepage.PNG (file) |  |
431 KB | OpenWetWare on the MIT homepage |
| 03:17, 19 November 2007 | LacI-MullerHill94.JPG (file) |  |
86 KB | Figure 1 from Muller-Hill et al. [EMBO J. 1994 July 15; 13(14): 3348–3355. http://www.pubmedcentral.nih.gov/articlerender.fcgi?artid=395232] |
| 06:25, 20 September 2007 | Ecoli.jpg (file) |  |
6 KB | A plush microbe from [http://www.giantmicrobes.com/us/products/ecoli.html Giant Microbes.com] |
| 20:40, 18 September 2007 | Patent squad memo-Breetz-1.doc (file) | 97 KB | Memo by Hanna Breetz evaluating the viability of the patent goon squad | |
| 18:34, 18 September 2007 | ESP-hairpinTest.PNG (file) |  |
38 KB | Experiment to test hairpin effectiveness in the empty screening plasmid. |
| 18:13, 18 September 2007 | ESP-promoterTest.PNG (file) |  |
78 KB | Results of experiment by Jason Kelly to look at possible promoter in the empty screening plasmid |
| 21:38, 11 September 2007 | 070909-pcr assemblyB.jpg (file) |  |
21 KB | |
| 21:36, 11 September 2007 | 070909-pcr assembly.jpg (file) |  |
21 KB | PCR fusion test gel |
| 03:07, 29 August 2007 | JK.SB3.0.Poster.2007.pdf (file) | 2.31 MB | Jason Kelly SB3.0 Poster | |
| 22:35, 10 August 2007 | IGEM06-Mint.JPG (file) |  |
23 KB | iGEM results for mint |
| 23:19, 13 June 2007 | 07.06.13.jpg (file) |  |
33 KB | Gel image |
| 23:46, 7 June 2007 | CFP-YFP plate reader comparison.PNG (file) |  |
8 KB | Comparison of CFP and YFP expressing cells in the plate reader. |
| 14:27, 6 June 2007 | IGEM-cropped-edited.PNG (file) |  |
1,010 KB | picture of MIT homage w 2006 iGEM team on it |
| 14:10, 6 June 2007 | Sortostat-valves-partialClosed.PNG (file) |  |
481 KB | Example of valves not sealing properly due to fabrication problems. |
| 21:17, 29 May 2007 | Sortostat v2.0 - whiteBG.JPG (file) |  |
69 KB | AutoCAD image of the Sortostat v2.0 design on white background with layers colored (blue = fluid, red = push UP, green = push DOWN) |
| 21:11, 29 May 2007 | Sortostat v2.0.PNG (file) |  |
47 KB | Autocad image of Sortostat v2.0 |
| 16:48, 22 May 2007 | Q04401InSp1.0.PNG (file) |  |
73 KB | Q04401 (mutant isolate from Q04400 library) in SP1.0 |
| 16:46, 22 May 2007 | Q04400LibInSP1.0.PNG (file) |  |
152 KB | Q04400 library in Sp1.0 |
| 16:42, 22 May 2007 | Q04400InverterInSP1.0.PNG (file) |  |
29 KB | Q04400 in SP1.0 |
| 16:40, 22 May 2007 | MntInverter.png (file) |  |
32 KB | Mnt-based inverter in SP1.0 |
| 09:43, 20 May 2007 | MofloBEADS-070520.png (file) |  |
23 KB | Example of what Spherotech RCP-60-5 Rainbow Calibration Particles (6.0-6.4um) should look like on the MOFLO under good alignment. 05/20/07 |
| 18:33, 5 May 2007 | DNA only horizontal.png (file) |  |
63 KB | no circle around emblem horizontal |
| 18:32, 5 May 2007 | DNAonly vertical.png (file) |  |
63 KB | shirt with no circle around logo |